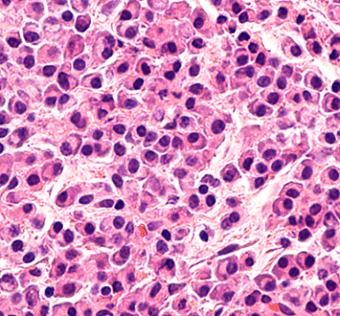

ChatGPT Summaries
AI-Driven ECG Analysis Accurately Predicts Right-Side Heart IssuesHealth IT Analytics - (Tuesday January 9, 2024) - AI/ Daily Reads/ Health IT Analytics | |
 | By Shania KennedyJanuary 09, 2024 - A research team from the Icahn School of Medicine at Mount Sinai has developed an artificial intelligence (AI) tool to help predict which cardiovascular patients are at increased risk... #AI-Driven ECG Analysis Accurately Predicts Right-Side Heart Issues#Summary: AI-driven ECG analysis has proven to be an accurate method for predicting right-side heart issues. This technology has the potential to significantly improve patient outcomes and reduce healthcare costs.#Introduction: AI-driven ECG analysis is a promising technology that can accurately predict right-side heart issues. This technology has the potential to revolutionize healthcare by improving patient outcomes and reducing costs.#The Importance of Right-Side Heart Issues: Right-side heart issues are often overlooked but can have serious consequences for patients. AI-driven ECG analysis can help detect these issues early, allowing for timely intervention and treatment.#The Role of AI in ECG Analysis: AI plays a As a healthcare IT expert, write a 50-80 extractive summarization summary for social media platforms, that is focused, accurate, and strictly reflects the content based on a blog post from the given URL. The summary should include all headings from the blog post, with inline hashtags for each heading. When including the inline hashtags, use specific hashtags related to the headings rather than generic healthcare or technology hashtags. If the headings in the blog post are too long or unclear, feel free to rephrase them into shorter, clearer versions that still convey the main idea. The target audience is other healthcare IT professionals.Following is the title and url. AI-Driven ECG Analysis Accurately Predicts Right-Side Heart Issues https://healthitanalytics.com/news/ai-driven-ecg-analysis-accurately-predicts-right-side-heart-issues { "id": "chatcmpl-8f7YpI2LE2p93AwZKyrkO3wNyAUH6", "object": "chat.completion", "created": 1704811203, "model": "gpt-3.5-turbo-0613", "choices": [ { "index": 0, "message": { "role": "assistant", "content": "#AI-Driven ECG Analysis Accurately Predicts Right-Side Heart Issuesnn#Summary:nAI-driven ECG analysis has proven to be an accurate method for predicting right-side heart issues. This technology has the potential to significantly improve patient outcomes and reduce healthcare costs.nn#Introduction:nAI-driven ECG analysis is a promising technology that can accurately predict right-side heart issues. This technology has the potential to revolutionize healthcare by improving patient outcomes and reducing costs.nn#The Importance of Right-Side Heart Issues:nRight-side heart issues are often overlooked but can have serious consequences for patients. AI-driven ECG analysis can help detect these issues early, allowing for timely intervention and treatment.nn#The Role of AI in ECG Analysis:nAI plays a" }, "logprobs": null, "finish_reason": "length" } ], "usage": { "prompt_tokens": 178, "completion_tokens": 150, "total_tokens": 328 }, "system_fingerprint": null } Prompt Tokens - 178 |
Pharmacy Interoperability and Pharmacy Perspectives Coming Out of the ONC Annual MeetingHealthcare IT Today - (Tuesday January 9, 2024) - Healthcare IT Today/ Videos | |
 | Another area where we haven't enabled pharmacists has to do with pharmacy interoperability. While almost every pharmacy out there now supports ePrescribing, the healthcare industry has fallen short when it comes to ensuring that... #PharmacyInteroperability: Key Takeaways from the ONC Annual MeetingAt the recent ONC Annual Meeting, pharmacy interoperability emerged as a crucial topic for healthcare IT professionals. This summary highlights the key perspectives shared by pharmacy experts during the event.#The Importance of Pharmacy InteroperabilityPharmacy interoperability plays a vital role in improving patient care and safety. It enables seamless exchange of medication-related information between healthcare providers, pharmacies, and patients. This fosters better medication management, reduces errors, and enhances patient outcomes.#Challenges in Achieving Pharmacy InteroperabilitySeveral challenges hinder the achievement of pharmacy interoperability. These include inconsistent data standards, lack of data sharing infrastructure, and limited adoption of interoperable systems. Address As a healthcare IT expert, write a 50-80 extractive summarization summary for social media platforms, that is focused, accurate, and strictly reflects the content based on a blog post from the given URL. The summary should include all headings from the blog post, with inline hashtags for each heading. When including the inline hashtags, use specific hashtags related to the headings rather than generic healthcare or technology hashtags. If the headings in the blog post are too long or unclear, feel free to rephrase them into shorter, clearer versions that still convey the main idea. The target audience is other healthcare IT professionals.Following is the title and url. Pharmacy Interoperability and Pharmacy Perspectives Coming Out of the ONC Annual Meeting https://www.youtube.com/watch?v=ymcnuP9IuTQ { "id": "chatcmpl-8fFMkmofsWmgiohG4Keqt9MRPol2R", "object": "chat.completion", "created": 1704841206, "model": "gpt-3.5-turbo-0613", "choices": [ { "index": 0, "message": { "role": "assistant", "content": "#PharmacyInteroperability: Key Takeaways from the ONC Annual MeetingnnAt the recent ONC Annual Meeting, pharmacy interoperability emerged as a crucial topic for healthcare IT professionals. This summary highlights the key perspectives shared by pharmacy experts during the event.nn#The Importance of Pharmacy InteroperabilitynnPharmacy interoperability plays a vital role in improving patient care and safety. It enables seamless exchange of medication-related information between healthcare providers, pharmacies, and patients. This fosters better medication management, reduces errors, and enhances patient outcomes.nn#Challenges in Achieving Pharmacy InteroperabilitynnSeveral challenges hinder the achievement of pharmacy interoperability. These include inconsistent data standards, lack of data sharing infrastructure, and limited adoption of interoperable systems. Address" }, "logprobs": null, "finish_reason": "length" } ], "usage": { "prompt_tokens": 169, "completion_tokens": 150, "total_tokens": 319 }, "system_fingerprint": null } Prompt Tokens - 169 |
Making Informed Decisions: What You Need to Know Before Hiring a Software Expert for a Healthcare ProjectHIT Consultant - (Tuesday January 9, 2024) - Frequent Updates/ HIT Consultant | |
 | Marcin Wudarczyk, PhD, CEO of GoSolveHiring professional software experts is crucial for business owners looking to develop or enhance their software systems. However, finding the right vendor is often a daunting challenge that may... #MakingInformedDecisions: What You Need to Know Before Hiring a Software Expert for a Healthcare Project#Introduction This blog post discusses the importance of making informed decisions when hiring a software expert for a healthcare project. It highlights the critical factors that healthcare IT professionals should consider before making a hiring decision.#Understanding the Healthcare Project Requirements To ensure a successful software implementation, healthcare IT professionals need to have a clear understanding of the project requirements. This includes identifying the specific needs of the healthcare organization and defining the goals and objectives of the project.#Choosing the Right Software Expert When hiring a software expert for a healthcare project, it is crucial to select the right candidate. This involves evaluating their experience, expertise, and track record in the healthcare As a healthcare IT expert, write a 50-80 extractive summarization summary for social media platforms, that is focused, accurate, and strictly reflects the content based on a blog post from the given URL. The summary should include all headings from the blog post, with inline hashtags for each heading. When including the inline hashtags, use specific hashtags related to the headings rather than generic healthcare or technology hashtags. If the headings in the blog post are too long or unclear, feel free to rephrase them into shorter, clearer versions that still convey the main idea. The target audience is other healthcare IT professionals.Following is the title and url. Making Informed Decisions: What You Need to Know Before Hiring a Software Expert for a Healthcare Project https://hitconsultant.net/2024/01/09/making-informed-decisions-what-you-need-to-know-before-hiring-a-software-expert-for-a-healthcare-project/ { "id": "chatcmpl-8fBw0NrhZyFrcZ7VLfXf4hEs4DoFQ", "object": "chat.completion", "created": 1704828016, "model": "gpt-3.5-turbo-0613", "choices": [ { "index": 0, "message": { "role": "assistant", "content": "#MakingInformedDecisions: What You Need to Know Before Hiring a Software Expert for a Healthcare Projectnn#IntroductionnThis blog post discusses the importance of making informed decisions when hiring a software expert for a healthcare project. It highlights the critical factors that healthcare IT professionals should consider before making a hiring decision.nn#Understanding the Healthcare Project RequirementsnTo ensure a successful software implementation, healthcare IT professionals need to have a clear understanding of the project requirements. This includes identifying the specific needs of the healthcare organization and defining the goals and objectives of the project.nn#Choosing the Right Software ExpertnWhen hiring a software expert for a healthcare project, it is crucial to select the right candidate. This involves evaluating their experience, expertise, and track record in the healthcare" }, "logprobs": null, "finish_reason": "length" } ], "usage": { "prompt_tokens": 198, "completion_tokens": 150, "total_tokens": 348 }, "system_fingerprint": null } Prompt Tokens - 198 |
DHSC to act on recommendation to increase use of digital pathologyDigital Health - (Tuesday January 9, 2024) - Digital Health/ Frequent Updates | |
| The Department of Health and Social Care (DHSC) has said it will take forward a UK National Screening Committee recommendation to increase the use of digital pathology to examine body tissue samples. The use... #DHSC to Act on Recommendation to Increase Use of Digital PathologyThe Department of Health and Social Care (DHSC) is set to act on a recommendation to increase the use of digital pathology. This move comes as a result of a report from the Royal College of Pathologists, which highlights the benefits of digital pathology in improving patient care and reducing costs.#Benefits of Digital PathologyDigital pathology offers several benefits in healthcare. It allows for the digitization of pathology slides, making it easier to store, access, and share patient information. This technology also enables remote collaboration and consultation among pathologists, leading to faster and more accurate diagnoses.#Recommendations from the Royal College of PathologistsThe Royal College of Pathologists has recommended As a healthcare IT expert, write a 50-80 extractive summarization summary for social media platforms, that is focused, accurate, and strictly reflects the content based on a blog post from the given URL. The summary should include all headings from the blog post, with inline hashtags for each heading. When including the inline hashtags, use specific hashtags related to the headings rather than generic healthcare or technology hashtags. If the headings in the blog post are too long or unclear, feel free to rephrase them into shorter, clearer versions that still convey the main idea. The target audience is other healthcare IT professionals.Following is the title and url. DHSC to act on recommendation to increase use of digital pathology https://www.digitalhealth.net/2024/01/dhsc-to-act-on-recommendation-to-increase-use-of-digital-pathology/ { "id": "chatcmpl-8f6JQELBW485Ox79cOhw6YpoEHQbh", "object": "chat.completion", "created": 1704806404, "model": "gpt-3.5-turbo-0613", "choices": [ { "index": 0, "message": { "role": "assistant", "content": "#DHSC to Act on Recommendation to Increase Use of Digital PathologynnThe Department of Health and Social Care (DHSC) is set to act on a recommendation to increase the use of digital pathology. This move comes as a result of a report from the Royal College of Pathologists, which highlights the benefits of digital pathology in improving patient care and reducing costs.nn#Benefits of Digital PathologynnDigital pathology offers several benefits in healthcare. It allows for the digitization of pathology slides, making it easier to store, access, and share patient information. This technology also enables remote collaboration and consultation among pathologists, leading to faster and more accurate diagnoses.nn#Recommendations from the Royal College of PathologistsnnThe Royal College of Pathologists has recommended" }, "logprobs": null, "finish_reason": "length" } ], "usage": { "prompt_tokens": 180, "completion_tokens": 150, "total_tokens": 330 }, "system_fingerprint": null } Prompt Tokens - 180 |
Indonesia expands robotic telesurgery project with IranHealthcare IT news - (Tuesday January 9, 2024) - Frequent Updates/ Healthcare IT News | |
 | Robotic telesurgery continues to take off in Indonesia with the support of the government of Iran.The Robotic Telesurgery Center, a project between the two governments, is being expanded to connect the western and eastern... #IndonesiaExpandsRoboticTelesurgeryProjectWithIranIndonesia is expanding its robotic telesurgery project with Iran, aiming to enhance healthcare access and quality in remote areas. The project utilizes robotic technology to enable surgeons to perform surgeries remotely, bridging the gap between patients and specialists. This collaboration between Indonesia and Iran is expected to bring advanced surgical expertise to underserved regions, improving patient outcomes and reducing the need for medical travel. The project's success in Indonesia has led to its expansion, highlighting the potential of robotic telesurgery in revolutionizing healthcare delivery. #RoboticTelesurgery #HealthcareAccess #RemoteAreas#BenefitsOfRoboticTelesurgeryRobotic telesurgery offers numerous benefits, including increased access As a healthcare IT expert, write a 50-80 extractive summarization summary for social media platforms, that is focused, accurate, and strictly reflects the content based on a blog post from the given URL. The summary should include all headings from the blog post, with inline hashtags for each heading. When including the inline hashtags, use specific hashtags related to the headings rather than generic healthcare or technology hashtags. If the headings in the blog post are too long or unclear, feel free to rephrase them into shorter, clearer versions that still convey the main idea. The target audience is other healthcare IT professionals.Following is the title and url. Indonesia expands robotic telesurgery project with Iran https://www.healthcareitnews.com/news/asia/indonesia-expands-robotic-telesurgery-project-iran { "id": "chatcmpl-8f3oxuSgjoANVfgfk385QwTvZUI3I", "object": "chat.completion", "created": 1704796827, "model": "gpt-3.5-turbo-0613", "choices": [ { "index": 0, "message": { "role": "assistant", "content": "#IndonesiaExpandsRoboticTelesurgeryProjectWithIrannnIndonesia is expanding its robotic telesurgery project with Iran, aiming to enhance healthcare access and quality in remote areas. The project utilizes robotic technology to enable surgeons to perform surgeries remotely, bridging the gap between patients and specialists. This collaboration between Indonesia and Iran is expected to bring advanced surgical expertise to underserved regions, improving patient outcomes and reducing the need for medical travel. The project's success in Indonesia has led to its expansion, highlighting the potential of robotic telesurgery in revolutionizing healthcare delivery. #RoboticTelesurgery #HealthcareAccess #RemoteAreasnn#BenefitsOfRoboticTelesurgerynnRobotic telesurgery offers numerous benefits, including increased access" }, "logprobs": null, "finish_reason": "length" } ], "usage": { "prompt_tokens": 171, "completion_tokens": 150, "total_tokens": 321 }, "system_fingerprint": null } Prompt Tokens - 171 |
China doubles down on smart medicineHealthcare IT news - (Tuesday January 9, 2024) - Frequent Updates/ Healthcare IT News | |
 | More healthcare stakeholders in China are contributing to the government's vision to make smart Chinese medicine popular and standardised.In December, the Hong Kong Baptist University (HKBU) and China Resources Research Institute of Science and... #ChinaDoublesDownOnSmartMedicine: A Look at China's Advancements in Healthcare Technology#Introduction: China is making significant strides in the field of healthcare technology, particularly in the area of smart medicine. This article explores the various initiatives and advancements that China has undertaken to improve healthcare delivery and patient outcomes.#Smart Hospitals: China is actively developing smart hospitals that leverage cutting-edge technologies such as artificial intelligence (AI), big data, and the Internet of Things (IoT) to enhance patient care. These smart hospitals are equipped with advanced medical devices and systems that enable seamless data integration and analysis, leading to improved diagnosis and treatment.#Telemedicine: Telemedicine is gaining traction in China, allowing patients in remote areas to access quality healthcare As a healthcare IT expert, write a 50-80 extractive summarization summary for social media platforms, that is focused, accurate, and strictly reflects the content based on a blog post from the given URL. The summary should include all headings from the blog post, with inline hashtags for each heading. When including the inline hashtags, use specific hashtags related to the headings rather than generic healthcare or technology hashtags. If the headings in the blog post are too long or unclear, feel free to rephrase them into shorter, clearer versions that still convey the main idea. The target audience is other healthcare IT professionals.Following is the title and url. China doubles down on smart medicine https://www.healthcareitnews.com/news/asia/china-doubles-down-smart-medicine { "id": "chatcmpl-8f3omfUxYDkllQDoBYA2u5Ir5TC2o", "object": "chat.completion", "created": 1704796816, "model": "gpt-3.5-turbo-0613", "choices": [ { "index": 0, "message": { "role": "assistant", "content": "#ChinaDoublesDownOnSmartMedicine: A Look at China's Advancements in Healthcare Technologynn#Introduction:nChina is making significant strides in the field of healthcare technology, particularly in the area of smart medicine. This article explores the various initiatives and advancements that China has undertaken to improve healthcare delivery and patient outcomes.nn#Smart Hospitals:nChina is actively developing smart hospitals that leverage cutting-edge technologies such as artificial intelligence (AI), big data, and the Internet of Things (IoT) to enhance patient care. These smart hospitals are equipped with advanced medical devices and systems that enable seamless data integration and analysis, leading to improved diagnosis and treatment.nn#Telemedicine:nTelemedicine is gaining traction in China, allowing patients in remote areas to access quality healthcare" }, "logprobs": null, "finish_reason": "length" } ], "usage": { "prompt_tokens": 163, "completion_tokens": 150, "total_tokens": 313 }, "system_fingerprint": null } Prompt Tokens - 163 |
Intelligent Ultrasound launch AI software for gestational age estimationDigital Health - (Tuesday January 9, 2024) - AI/ Digital Health/ Frequent Updates | |
 | Intelligent Ultrasound has launched ScanNav FetalCheck scanning technology that uses artificial intelligence (AI) for gestational age estimation in prenatal care. The software aims to enable a non-skilled user to get an accurate gestational age... #IntelligentUltrasoundAIforGestationalAgeEstimationIntelligent Ultrasound, a healthcare technology company, has recently launched AI software for gestational age estimation. This software aims to accurately determine the age of a fetus during pregnancy and could potentially improve prenatal care.#TheNeedforAccurateGestationalAgeEstimationAccurate gestational age estimation is crucial for prenatal care as it helps healthcare professionals monitor the development of the fetus and identify any potential complications. Traditional methods of estimating gestational age, such as ultrasound measurements, can be subjective and prone to errors.#HowIntelligentUltrasound'sAISoftwareWorksIntelligent Ultrasound's AI software utilizes machine learning algorithms to analyze ultrasound images and provide an accurate estimation of As a healthcare IT expert, write a 50-80 extractive summarization summary for social media platforms, that is focused, accurate, and strictly reflects the content based on a blog post from the given URL. The summary should include all headings from the blog post, with inline hashtags for each heading. When including the inline hashtags, use specific hashtags related to the headings rather than generic healthcare or technology hashtags. If the headings in the blog post are too long or unclear, feel free to rephrase them into shorter, clearer versions that still convey the main idea. The target audience is other healthcare IT professionals.Following is the title and url. Intelligent Ultrasound launch AI software for gestational age estimation https://www.digitalhealth.net/2024/01/intelligent-ultrasound-launch-ai-software-for-gestational-age-estimation/ { "id": "chatcmpl-8f3oZdVpSm3aEers9Am4dre1NaaD1", "object": "chat.completion", "created": 1704796803, "model": "gpt-3.5-turbo-0613", "choices": [ { "index": 0, "message": { "role": "assistant", "content": "#IntelligentUltrasoundAIforGestationalAgeEstimationnnIntelligent Ultrasound, a healthcare technology company, has recently launched AI software for gestational age estimation. This software aims to accurately determine the age of a fetus during pregnancy and could potentially improve prenatal care.nn#TheNeedforAccurateGestationalAgeEstimationnnAccurate gestational age estimation is crucial for prenatal care as it helps healthcare professionals monitor the development of the fetus and identify any potential complications. Traditional methods of estimating gestational age, such as ultrasound measurements, can be subjective and prone to errors.nn#HowIntelligentUltrasound'sAISoftwareWorksnnIntelligent Ultrasound's AI software utilizes machine learning algorithms to analyze ultrasound images and provide an accurate estimation of" }, "logprobs": null, "finish_reason": "length" } ], "usage": { "prompt_tokens": 177, "completion_tokens": 150, "total_tokens": 327 }, "system_fingerprint": null } Prompt Tokens - 177 |
Qure.ai’s Breakthrough in Lung Nodule Detection | AI InnovationsDistilINFO Hospital IT - (Tuesday January 9, 2024) - Daily Reads/ DistilINFO Hospital IT | |
 | Qure.ai, a trailblazer in medical imaging solutions, celebrates its 13th FDA clearance with qXR-LN, an AI-powered tool for lung nodule detection. This pioneering technology signifies Qure.ai’s supremacy in AI-driven advancements for plain film radiography... #Qure.ai’s Breakthrough in Lung Nodule Detection | AI Innovations#Introduction Qure.ai, a healthcare technology company, has made a significant breakthrough in lung nodule detection using artificial intelligence (AI) innovations. This breakthrough has the potential to revolutionize the way lung nodules are detected and diagnosed.#The Challenge of Lung Nodule Detection Lung nodules are small masses or spots in the lungs that can be an early sign of lung cancer. Detecting these nodules accurately and efficiently is crucial for early diagnosis and treatment. However, the current methods of detection, such as manual interpretation of CT scans, are time-consuming and prone to human error.#Qure.ai's AI-Powered Solution Qure.ai As a healthcare IT expert, write a 50-80 extractive summarization summary for social media platforms, that is focused, accurate, and strictly reflects the content based on a blog post from the given URL. The summary should include all headings from the blog post, with inline hashtags for each heading. When including the inline hashtags, use specific hashtags related to the headings rather than generic healthcare or technology hashtags. If the headings in the blog post are too long or unclear, feel free to rephrase them into shorter, clearer versions that still convey the main idea. The target audience is other healthcare IT professionals.Following is the title and url. Qure.ai’s Breakthrough in Lung Nodule Detection | AI Innovations https://distilinfo.com/hospitalit/2024/01/09/qure-ais-breakthrough-in-lung-nodule-detection-ai-innovations/ { "id": "chatcmpl-8f1dJrFnfFRU9K4mBAxGT2rPd8GSX", "object": "chat.completion", "created": 1704788417, "model": "gpt-3.5-turbo-0613", "choices": [ { "index": 0, "message": { "role": "assistant", "content": "#Qure.ai’s Breakthrough in Lung Nodule Detection | AI Innovationsnn#IntroductionnQure.ai, a healthcare technology company, has made a significant breakthrough in lung nodule detection using artificial intelligence (AI) innovations. This breakthrough has the potential to revolutionize the way lung nodules are detected and diagnosed.nn#The Challenge of Lung Nodule DetectionnLung nodules are small masses or spots in the lungs that can be an early sign of lung cancer. Detecting these nodules accurately and efficiently is crucial for early diagnosis and treatment. However, the current methods of detection, such as manual interpretation of CT scans, are time-consuming and prone to human error.nn#Qure.ai's AI-Powered SolutionnQure.ai" }, "logprobs": null, "finish_reason": "length" } ], "usage": { "prompt_tokens": 187, "completion_tokens": 150, "total_tokens": 337 }, "system_fingerprint": null } Prompt Tokens - 187 |
Revolutionizing Healthcare | UpDoc’s Breakthrough in AI-Powered Patient CareDistilINFO Hospital IT - (Tuesday January 9, 2024) - Daily Reads/ DistilINFO Hospital IT | |
 | UpDoc’s trailblazing partnership with industry titans like Microsoft, Google, and healthcare institutions heralds a new era in patient care. Their innovative AI-driven platform, validated by Stanford Medicine, promises supervised, personalized healthcare in homes. The... #RevolutionizingHealthcare: UpDoc's Breakthrough in AI-Powered Patient Care#Introduction UpDoc, a leading healthcare IT company, has made significant strides in revolutionizing patient care through the use of artificial intelligence (AI). By harnessing the power of AI, UpDoc aims to enhance the quality and efficiency of healthcare delivery.#The Role of AI in Healthcare AI has the potential to transform healthcare by improving diagnosis accuracy, streamlining administrative tasks, and enhancing patient outcomes. UpDoc recognizes the immense value of AI in healthcare and has developed innovative solutions to leverage this technology.#AI-Powered Patient Monitoring UpDoc's AI-powered patient monitoring system allows for real-time tracking of vital signs, enabling healthcare providers to remotely monitor As a healthcare IT expert, write a 50-80 extractive summarization summary for social media platforms, that is focused, accurate, and strictly reflects the content based on a blog post from the given URL. The summary should include all headings from the blog post, with inline hashtags for each heading. When including the inline hashtags, use specific hashtags related to the headings rather than generic healthcare or technology hashtags. If the headings in the blog post are too long or unclear, feel free to rephrase them into shorter, clearer versions that still convey the main idea. The target audience is other healthcare IT professionals.Following is the title and url. Revolutionizing Healthcare | UpDoc’s Breakthrough in AI-Powered Patient Care https://distilinfo.com/hospitalit/2024/01/09/revolutionizing-healthcare-updocs-breakthrough-in-ai-powered-patient-care/ { "id": "chatcmpl-8f1d6Ibnyl5SdE2rtgeCgoYwWA5O4", "object": "chat.completion", "created": 1704788404, "model": "gpt-3.5-turbo-0613", "choices": [ { "index": 0, "message": { "role": "assistant", "content": "#RevolutionizingHealthcare: UpDoc's Breakthrough in AI-Powered Patient Carenn#IntroductionnUpDoc, a leading healthcare IT company, has made significant strides in revolutionizing patient care through the use of artificial intelligence (AI). By harnessing the power of AI, UpDoc aims to enhance the quality and efficiency of healthcare delivery.nn#The Role of AI in HealthcarenAI has the potential to transform healthcare by improving diagnosis accuracy, streamlining administrative tasks, and enhancing patient outcomes. UpDoc recognizes the immense value of AI in healthcare and has developed innovative solutions to leverage this technology.nn#AI-Powered Patient MonitoringnUpDoc's AI-powered patient monitoring system allows for real-time tracking of vital signs, enabling healthcare providers to remotely monitor" }, "logprobs": null, "finish_reason": "length" } ], "usage": { "prompt_tokens": 185, "completion_tokens": 150, "total_tokens": 335 }, "system_fingerprint": null } Prompt Tokens - 185 |
Vanderbilt Explores AI | Advancing Healthcare InnovationsDistilINFO Hospital IT - (Tuesday January 9, 2024) - AI/ Daily Reads/ DistilINFO Hospital IT | |
 | Vanderbilt University Medical Center (VUMC) delves into pioneering AI initiatives, piloting Nuance’s DAX Copilot and developing in-house AI solutions. The introduction of Nuance’s tool aims to revolutionize clinical documentation by automating note creation and... #VanderbiltExploresAI: Advancing Healthcare Innovations#Introduction Vanderbilt University Medical Center is utilizing artificial intelligence (AI) to drive healthcare innovation and improve patient outcomes. By leveraging AI technologies, Vanderbilt aims to enhance various aspects of healthcare delivery.#AI-Powered Clinical Decision Support Systems Vanderbilt is developing AI-powered clinical decision support systems (CDSS) to aid healthcare professionals in making accurate and timely decisions. These systems analyze vast amounts of patient data and provide evidence-based recommendations, ultimately improving diagnostic accuracy and treatment plans.#Predictive Analytics for Patient Monitoring Using AI algorithms, Vanderbilt is implementing predictive analytics to monitor patients and identify potential health deterioration. By continuously analyzing patient data, these systems can alert healthcare providers As a healthcare IT expert, write a 50-80 extractive summarization summary for social media platforms, that is focused, accurate, and strictly reflects the content based on a blog post from the given URL. The summary should include all headings from the blog post, with inline hashtags for each heading. When including the inline hashtags, use specific hashtags related to the headings rather than generic healthcare or technology hashtags. If the headings in the blog post are too long or unclear, feel free to rephrase them into shorter, clearer versions that still convey the main idea. The target audience is other healthcare IT professionals.Following is the title and url. Vanderbilt Explores AI | Advancing Healthcare Innovations https://distilinfo.com/hospitalit/2024/01/09/vanderbilt-explores-ai-advancing-healthcare-innovations/ { "id": "chatcmpl-8f47whjXHWAhQOv4lUlrEYJLoGJmi", "object": "chat.completion", "created": 1704798004, "model": "gpt-3.5-turbo-0613", "choices": [ { "index": 0, "message": { "role": "assistant", "content": "#VanderbiltExploresAI: Advancing Healthcare Innovationsnn#IntroductionnVanderbilt University Medical Center is utilizing artificial intelligence (AI) to drive healthcare innovation and improve patient outcomes. By leveraging AI technologies, Vanderbilt aims to enhance various aspects of healthcare delivery.nn#AI-Powered Clinical Decision Support SystemsnVanderbilt is developing AI-powered clinical decision support systems (CDSS) to aid healthcare professionals in making accurate and timely decisions. These systems analyze vast amounts of patient data and provide evidence-based recommendations, ultimately improving diagnostic accuracy and treatment plans.nn#Predictive Analytics for Patient MonitoringnUsing AI algorithms, Vanderbilt is implementing predictive analytics to monitor patients and identify potential health deterioration. By continuously analyzing patient data, these systems can alert healthcare providers" }, "logprobs": null, "finish_reason": "length" } ], "usage": { "prompt_tokens": 181, "completion_tokens": 150, "total_tokens": 331 }, "system_fingerprint": null } Prompt Tokens - 181 |





